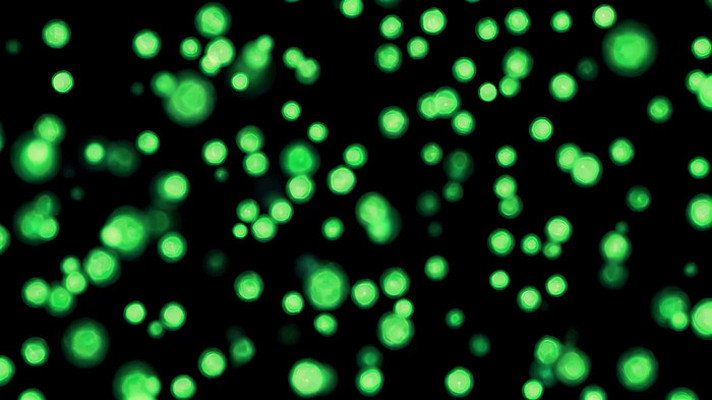
ɫӱز

全部
- 全部
- 摄影图
搜索
705结果
或
找人设计